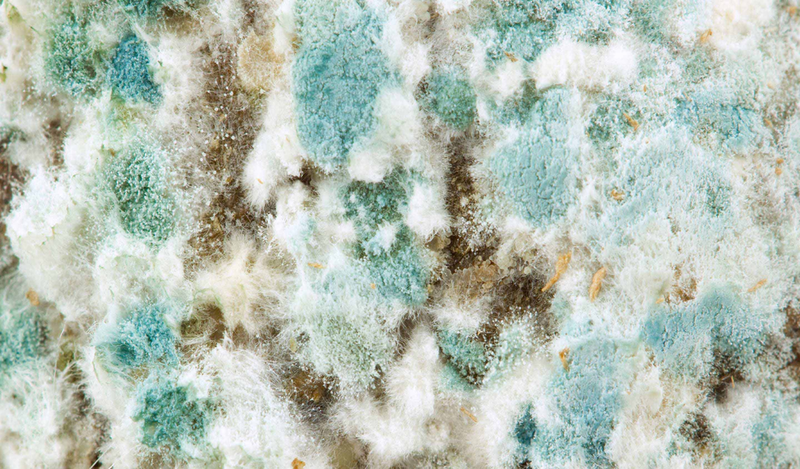
Cach-bao-quan-banh-trang-phoi-suong 5.png

Bánh tráng phơi sương là một trong những món đặc sản dân dã và quen thuộc của người Việt Nam. Món bánh này có thể ăn trực tiếp, hoặc chế biến thành những món ăn như bánh tráng trộn, bánh tráng nướng, hoặc kết hợp với các nguyên liệu khác để được một món ăn ngon như gỏi cuốn,... Để có được một miếng bánh tráng phơi sương ngon cần nhiều công sức và thời gian. Bên cạnh quy trình làm ra bánh thì cách bảo quản thực phẩm, cụ thể là bánh tráng phơi sương không bị khô, mốc cũng góp phần đảm bảo chất lượng và độ ngon của bánh.
Cách làm ra một chiếc bánh tráng phơi sương ngon
Bánh tráng phơi sương nổi tiếng là đặc sản ở vùng Trảng Bàng thuộc tỉnh Tây Ninh. Bánh tráng phơi sương có đặc tính dai dẻo, vị mặn nhẹ, có hình tròn, màu trắng, trên bề mặt bánh có đôi khi sẽ có các hạt bong bóng nhỏ.
Với những nguyên liệu cực kỳ đơn giản như bột gạo, nước và muối mà những người thợ làm bánh lành nghề đã có thể đong đếm tỉ lệ các nguyên liệu một cách khéo léo để cho ra hỗn hợp bột ngon để tráng bánh.
 Phơi dưới nắng mặt trời giúp bánh tráng được dẻo và dai hơn
Phơi dưới nắng mặt trời giúp bánh tráng được dẻo và dai hơnQuy trình làm bánh gồm các công đoạn sau:
Xay bột: Gạo sẽ được vo sạch, xay thành bột, tùy theo công thức ở mỗi nơi mà người làm bánh sẽ pha thêm bột mì hoặc bột năng và hỗn hợp bột để làm tăng sự dẻo, dai. Sau đó hoà vào một lượng nhỏ muối, đổ hỗn hợp bột qua rây để loại bỏ tạp cũng như những khối bột chưa tan hết. Cho hỗn hợp bột nghỉ 20 - 30 phút trước khi tráng bánh.
Tráng bánh: Chuẩn bị một nồi nước lớn trên bếp, bọc một lớp vải trắng sạch, dày trên bề mặt. Đợi khi nước sôi và bốc hơi nhiều thì đổ hỗn hợp bột gạo đã pha lên tấm vải, dùng muỗng hoặc vá to tráng bột ra cho tròn đều. Đậy nắp và đợi bánh chín, khi bánh chín sẽ đặc lại thành lớp mỏng, có thể dùng que tre hoặc đũa lấy bánh ra, trải đều trên vỉ tre rồi đem phơi.
Phơi nắng: Đem các vỉ tre ra phơi trực tiếp dưới ánh nắng mặt trời từ 3 - 4 tiếng hoặc đến khi bánh se lại, mang vào chỗ mát.
Nướng bánh: Nướng bằng lò than đến khi bánh có màu trắng đục, mặt nổi bóng li ti thì lấy ra ngay để tránh cháy bánh.
Phơi sương: Khi sương xuống nhiều vào ban đêm, trải đều bánh trên vỉ tre rồi mang phơi, đến tờ mờ sáng sẽ lấy bánh vào, lót vào túi đựng một tấm lá chuối sẽ giúp bánh giữ độ dẻo.
Là một loại thực phẩm có quy trình sản xuất tiếp xúc nhiều với môi trường thiên nhiên nên cũng sẽ làm tăng khả năng tiếp xúc với các vi khuẩn, bào tử nấm mốc lơ lửng trong không khí. Khi gặp được điều kiện thuận lợi sẽ phát triển thành nấm mốc, nếu không may ăn phải bánh tráng bị mốc có thể gây nôn, buồn nôn, tiêu chảy,... Do đó, cách bảo quản bánh tráng phơi sương đúng cách để tận hưởng món ăn vặt hấp dẫn này cũng là điều quan trọng.
 Bảo quản trong tủ lạnh cũng là một trong những cách bảo quản bánh tráng phơi sương
Bảo quản trong tủ lạnh cũng là một trong những cách bảo quản bánh tráng phơi sươngCách bảo quản bánh tráng phơi sương đúng cách
Bánh tráng phơi sương món bánh được nhiều người ưa chuộng không chỉ vì hương vị đặc trưng mà còn vì độ dẻo và dai đặc biệt. Tuy nhiên, bánh tráng sau khi mua về cần được bảo quản đúng cách để giữ được độ ngon, tránh ẩm mốc và kéo dài thời gian sử dụng. Dưới đây là một số cách bảo quản bánh tráng phơi sương thường được áp dụng:
- Bảo quản nơi khô ráo, thoáng mát: Bạn nên cất bánh tráng ở nơi khô ráo, tránh ánh nắng trực tiếp và xa khu vực có hơi nước. Nhiệt độ và độ ẩm cao là môi trường lý tưởng cho vi khuẩn phát triển, tạo thành nấm mốc làm hỏng bánh tráng.
- Dùng túi zip đựng bánh tráng: Để bảo quản bánh tráng sau khi đã mở gói, bạn nên dùng túi zip để đựng. Trước khi đóng túi, hãy chắc chắn đã loại bỏ hết không khí ra khỏi túi. Cách này giúp bánh tráng giữ được độ giòn lâu hơn.
- Bảo quản bằng hộp kín: Nếu bạn có nhiều bánh tráng, việc sử dụng hộp kín để cất giữ cũng là một sự lựa chọn tốt. Hộp kín cũng giúp bánh tráng tránh được việc tiếp xúc với không khí, từ đó hạn chế được tình trạng ẩm mốc.
- Bảo quản trong tủ lạnh: Đối với thời gian bảo quản dài, bạn có thể cất bánh tráng vào tủ lạnh. Tuy nhiên, khi sử dụng lại bạn cần lấy bánh tráng ra nhiệt độ phòng khoảng 15 - 20 phút để bánh trở lại độ dai tự nhiên trước khi sử dụng bánh.
Lưu ý khi bảo quản bánh tráng phơi sương
Trong quá trình bảo quản bánh tráng phơi sương, bạn cũng cần lưu ý một số điều như sau:
- Trong hộp bảo quản hoặc túi zip có thể đặt thêm túi hút ẩm. Túi hút ẩm sẽ giúp duy trì độ khô ráo cho bánh tráng, giảm thiểu khả năng bị mốc.
- Dù đã bảo quản cẩn thận, bạn cũng nên thường xuyên kiểm tra tình trạng của bánh tráng, đặc biệt nếu bảo quản trong thời gian dài. Bất kỳ dấu hiệu nào của việc nấm mốc hoặc thay đổi về mùi, màu sắc cũng cần được chú ý.
- Chia nhỏ bánh tráng ra từng phần nhỏ, mỗi phần từ 5 - 10 miếng bánh tráng. Khi sử dụng lấy ra từng phần để tránh ảnh hưởng đến những bánh chưa dùng đến.
- Không để bánh tráng ở gần các thiết bị tạo gió như quạt, máy lạnh vì bánh sẽ nhanh bị cứng và khô lại.
- Treo hoặc để bánh mở những nơi khô ráo, thoáng mát để tránh các loại côn trùng, kiến, gián, chuột,...
 Lót một phần lá chuối vào túi đựng bánh tráng giúp bánh tráng dẻo và dai
Lót một phần lá chuối vào túi đựng bánh tráng giúp bánh tráng dẻo và daiTừ đó có thể thấy, cần chú trọng vào các cách bảo quản bánh tráng phơi sương để đảm bảo bánh giữ được hương vị, độ ngon của bánh. Hãy áp dụng những cách trên để kéo dài thời gian sử dụng của bánh tráng nhé!
Một số điều cần lưu ý khi sử dụng bánh tráng phơi sương
Bánh tráng phơi sương bị hỏng là khi có sự xuất hiện của nấm mốc, nấm mốc thường có màu xanh, xanh đen hoặc trắng. Kèm theo đó là mùi ẩm mốc khá nồng. Một số người bị dị ứng với mùi nấm mốc, nếu ngửi phải có thể gây khó thở, hắt hơi,...
Nếu ăn phải bánh tráng phơi sương có thể bị rối loạn tiêu hoá như nôn mửa, choáng, tiêu chảy,... Không nên ăn những phần bánh tráng đã được loại bỏ phần nấm mốc cũng như các thực phẩm bị mốc vì việc đó có thể gây nên tình trạng tích tụ độc tố vi nấm gây nên những bệnh lý nghiêm trọng như suy thận, ung thư gan,...
Nấm mốc gây ra nhiều ảnh hưởng có hại cho sức khoẻ
Nấm mốc gây ra nhiều ảnh hưởng có hại cho sức khoẻ Một số người tiêu dùng khi thấy bánh tráng phơi sương xuất hiện vài đốm nhỏ nấm mốc, thấy số lượng nấm mốc không nhiều liền phủi bỏ, phơi nắng hoặc cắt bỏ phần bánh có nấm mốc. Tuy nhiên, những bào tử vi nấm không thật sự được loại bỏ hoàn toàn. Vì vậy, hãy vì sức khỏe của bản thân, khi thấy nấm mốc xuất hiện hãy bỏ ngay phần bánh tráng ấy.
Với những cách bảo quản bánh tráng phơi sương được Nhà thuốc Long Châu chia sẻ trong bài, mong rằng các bạn đọc có thể tìm được cách bảo quản phù hợp với điều kiện của gia đình.
Xem thêm: Những mẹo giúp bảo quản gừng tươi lâu hơn


